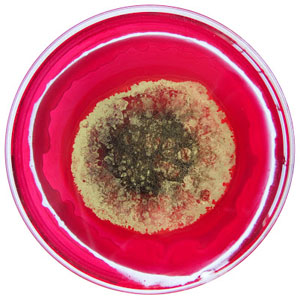
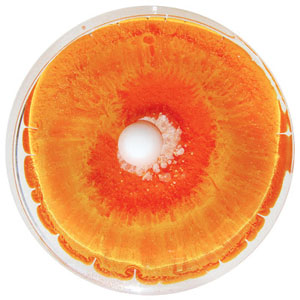
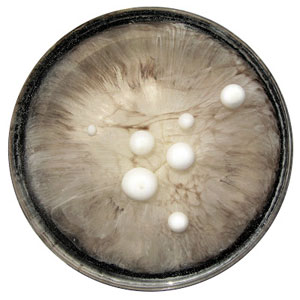
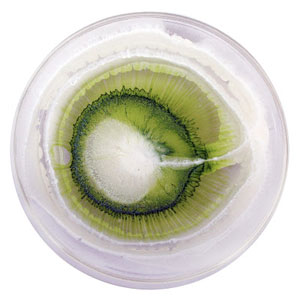

絢麗迷幻又令人卻步的培養皿藝術
‧本文由 活得精彩 分享 ‧
2013-03-10 ‧
顯示 3,368 次
‧
轉寄 32 次
‧
短評 0 篇
‧


上過自然科學都知道,培養皿是觀察生物生存機制的最好載器(還有土司也是XD),如果放著一段時間不去管它,等暮然回首的時候,會發現已經超展開到達一個新世界的境界,藝術家 Klari Reis 憑藉著愛好繪畫與科學的心,利用培養皿記錄了自然界的奧妙,並且取了一個貼切的名字,真是藝術家的浪漫。
Klari Reis
會製作這系列作品的契機是因為她 20 歲時被診斷出罹患了 Crohn's
Disease(慢性的腸道炎症),在被檢測的過程中發現了培養皿上多采多姿的神祕世界,因此開始研究及實驗,最後利用環氧聚合物以及染料交互作用下,呈現出了美麗的色彩與紋理,觀賞者似乎可以在這些彩色的培養皿中看見生命的躍動。


▲(左)3.3 Underwater Pen Marks 水下的筆跡 / (右)3.1 Rough Rouge 狂野胭脂


▲(左)2.28 Sun with Acne 太陽粉刺 / (右)2.27 Pretty in Pink 紅粉佳人

▲(左)2.26 Purple Moon Rocks 紫色月球石 / (右)2.25 Jennifer Aniston 珍妮佛˙安妮斯頓


▲(左)2.24 Eggplants in the Snow 雪地中的茄子 / (右)2.20 Silver Dollar Tan 銀元皮件


▲(左)2.19 TadPoles 蝌蚪 / (右)2.18 Clam Mouth 蛤蠣嘴


▲(左)2.17 Midas in Winter 冬天的麥達斯 / (右)2.16 Blue Tango 藍色探戈

▲(左)2.15 Jupiter 木星 / (右)2.14 Strawberry Short Cake 草莓酥餅


▲(左)2.13 Sea Shell in Love 戀愛海貝 / (右)2.12 Cherry with a Smile 微笑櫻桃


▲(左)2.11 Blue Angels 藍色天使 / (右)2.10 Baboon 狒狒

▲(左)2.9 Blue Skittle in the Microwave 微波爐中的藍色彩虹糖 / (左)2.8 Foreign Constellations 異國星座


▲(左)2.7 Paris Hilton 派瑞斯˙希爾頓 / (右)2.6 Quicksand 流沙


▲(左)2.5 Octopus Kisses 章魚之吻 / (右)2.4 Funky Onion 發霉洋蔥


▲(左)2.3 Froggy Water 有青蛙的水塘 / (右)2.2 Prince 王子


▲(左)2.1 Raspberry Punch 覆盆子調酒 / (右)1.31 Queen of Hearts 紅心皇后


▲(左)1.30 Angel is a Centerfold 天使是折頁(出自一首歌的歌名:這裡。意思是他喜歡的女生是在雜誌上折頁所看到的女孩) / (右)1.29 Beam me up Scotty「史考提,把我傳送上去!」(此句為星艦迷航記中的一句話,後來成為流行語之一)


▲(左)1.28 Dancing Bugs 錯誤舞步 / (右)1.27 Strawberry Sally 草莓沙莉


▲(左)1.26 Absinthe on the Rocks 岩石上的苦艾酒 / (右)1.25 Lava Rama 熔岩拉瑪


▲(左)1.24 Prom Dress After Blue Berry Pie 吃完藍莓派後的舞會禮服 / (右)1.23 Lady Gaga


▲(左)1.22 Chubby Brown Flowers 胖呼呼圓滾滾的褐色花 / (右)1.21 The Case of the Mondays 週一症候群


▲(左)1.20 Orange Julius(國外的連鎖的果汁飲料冷飲店) / (右)1.19 Disproportionate Pizza from the Unknown 不知道是誰送來的不成比例的比薩

▲(左)1.18 That Party Last Friday 上週五的派對 / (右)1.17 Lily Pad on a Frozen Pond 結冰池塘裡的荷葉


▲(左)1,16 EMO / (右)1.15 Moshing at a Pearl Jam Concert 珍珠果醬演唱會裡的重金屬狂舞
在 2013 年,Klari Reis 每天都會新增一個新創作的培養皿,取上有點令人噗疵一笑不知所以的名字,顏色絢麗的程度讓人忍不住每天都上部落格看看今天有什麼新的創意阿!
0.00
0 votes
1
3
5
7
9
請按數字進行評分
請以1~9的評分代表由負面到正面的感受,統計數據將決定資訊的參考價值。謝謝!
|
關鍵字建檔說明
|
顯示/隱藏
列印
列印提示
- 您可以點擊右方的「顯示/隱藏」鏈結來隱藏不相關的內容。
- 內容確認後,點擊右方的「列印」鏈結或瀏覽器之列印鍵即可。
- 完成後,顯示被隱藏的內容即可繼續瀏覽。

